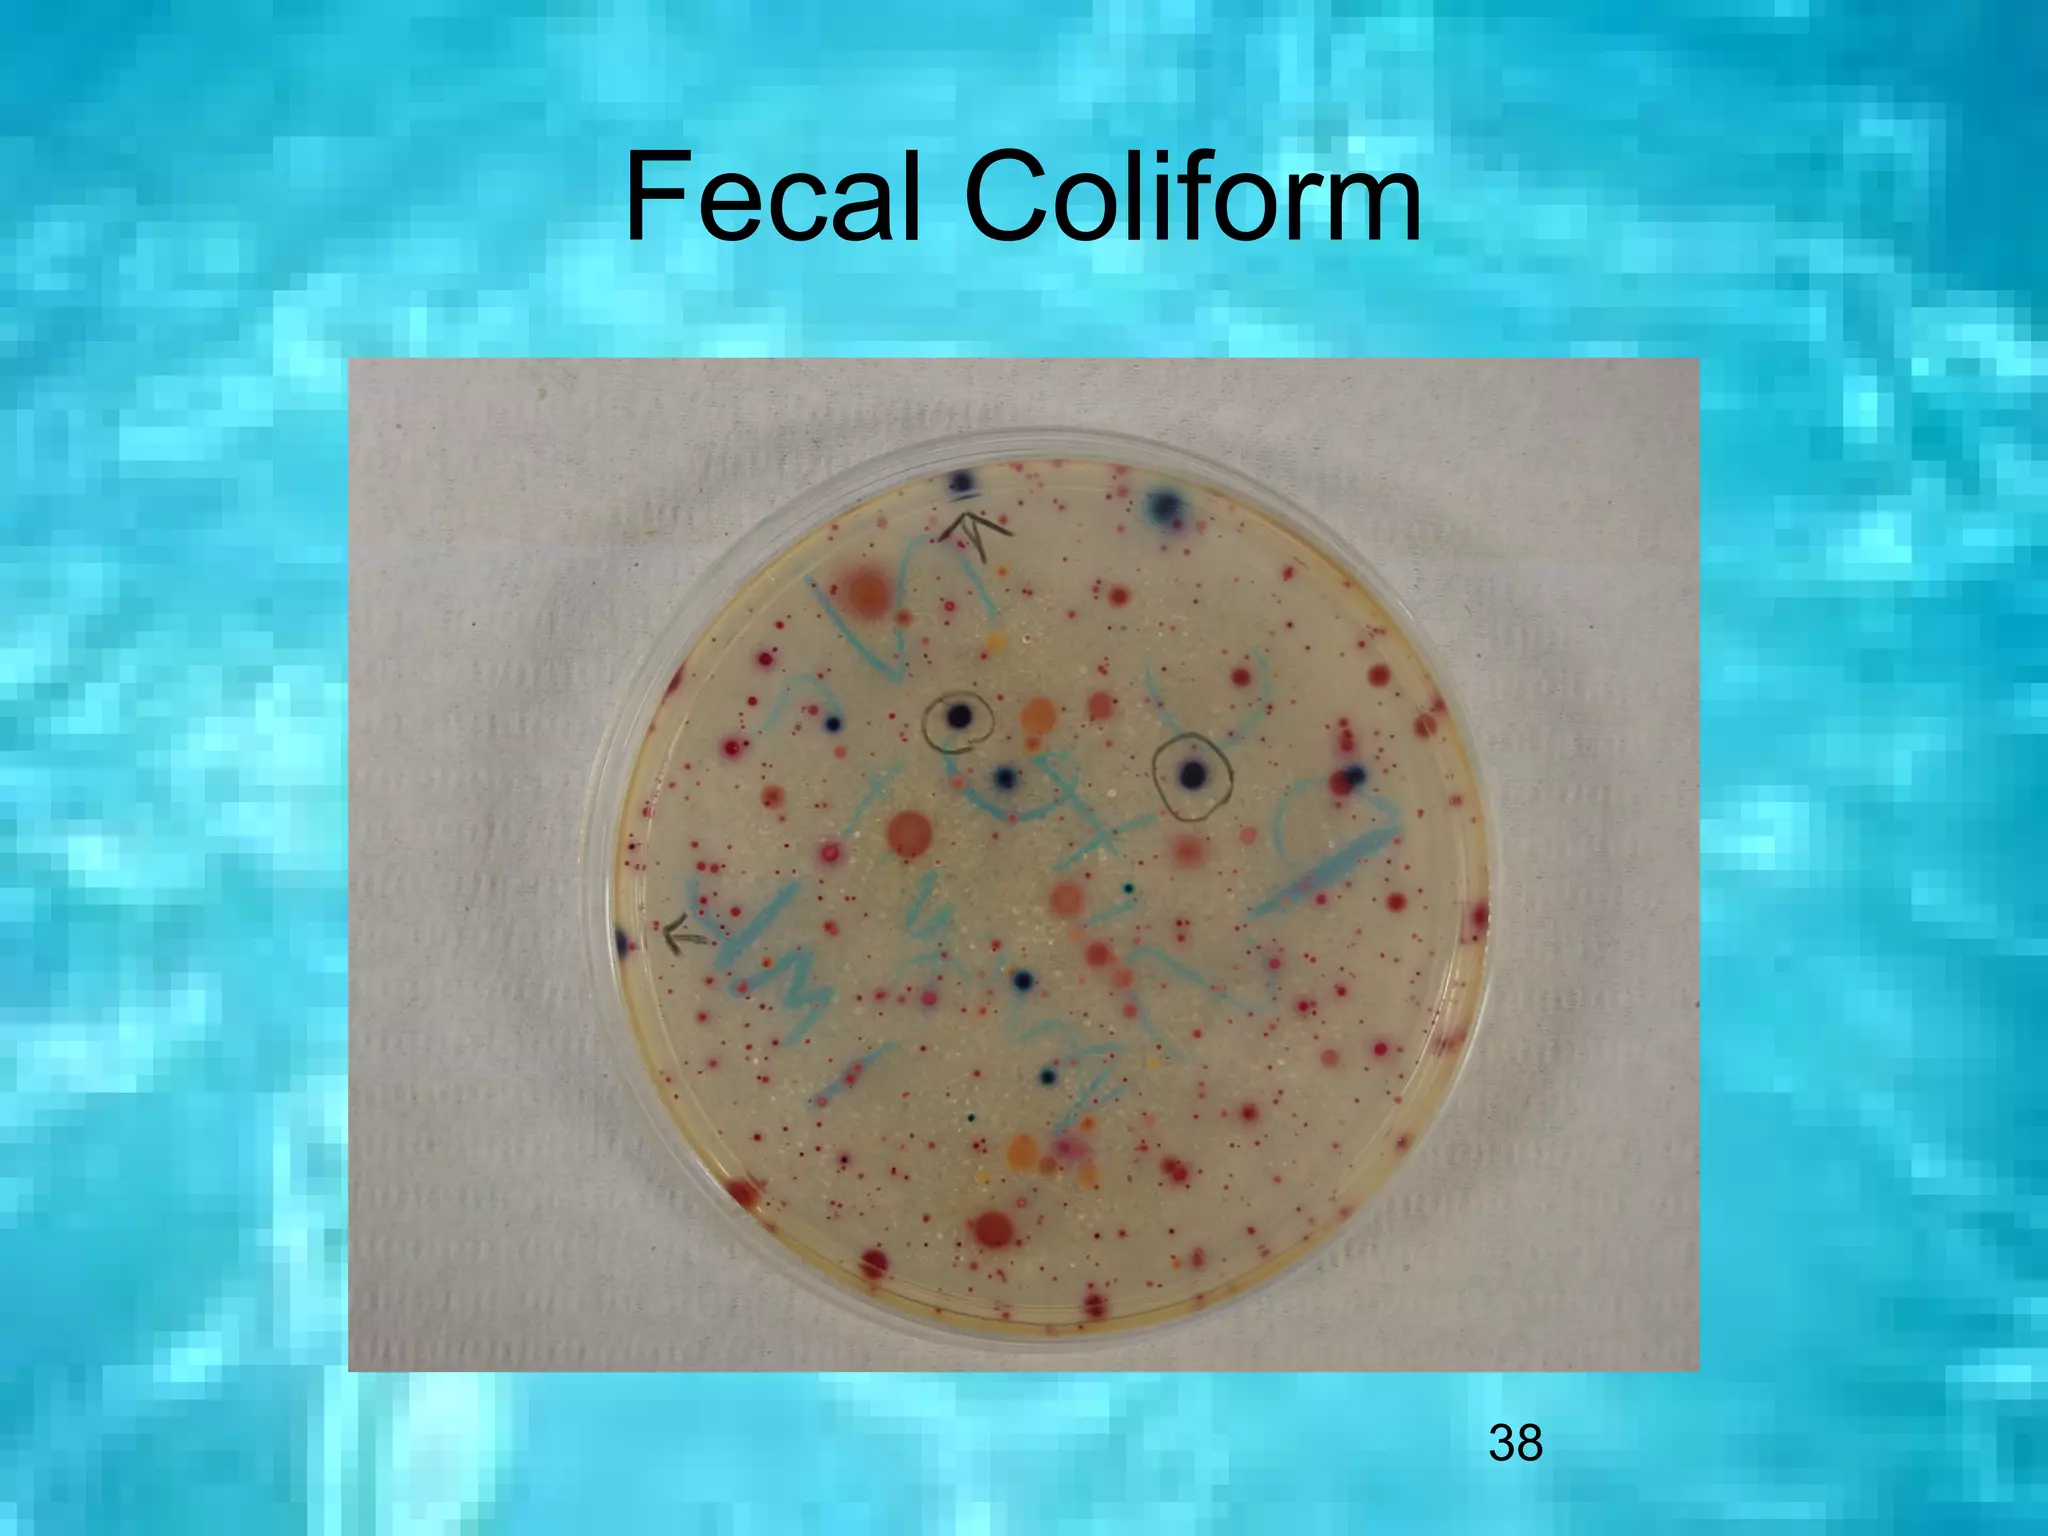
Fecal Coliform




                 38

The 2004 Shell Creek Watershed Study was conducted by 16 researchers under the advisement of Mark Seier. Over the course of three sampling periods in May, June, and August, water quality tests were performed at 5 sites on Shell Creek to determine the Water Quality Index. Test results showed medium water quality across most sites and periods, with some sites scoring in the good range on individual tests.